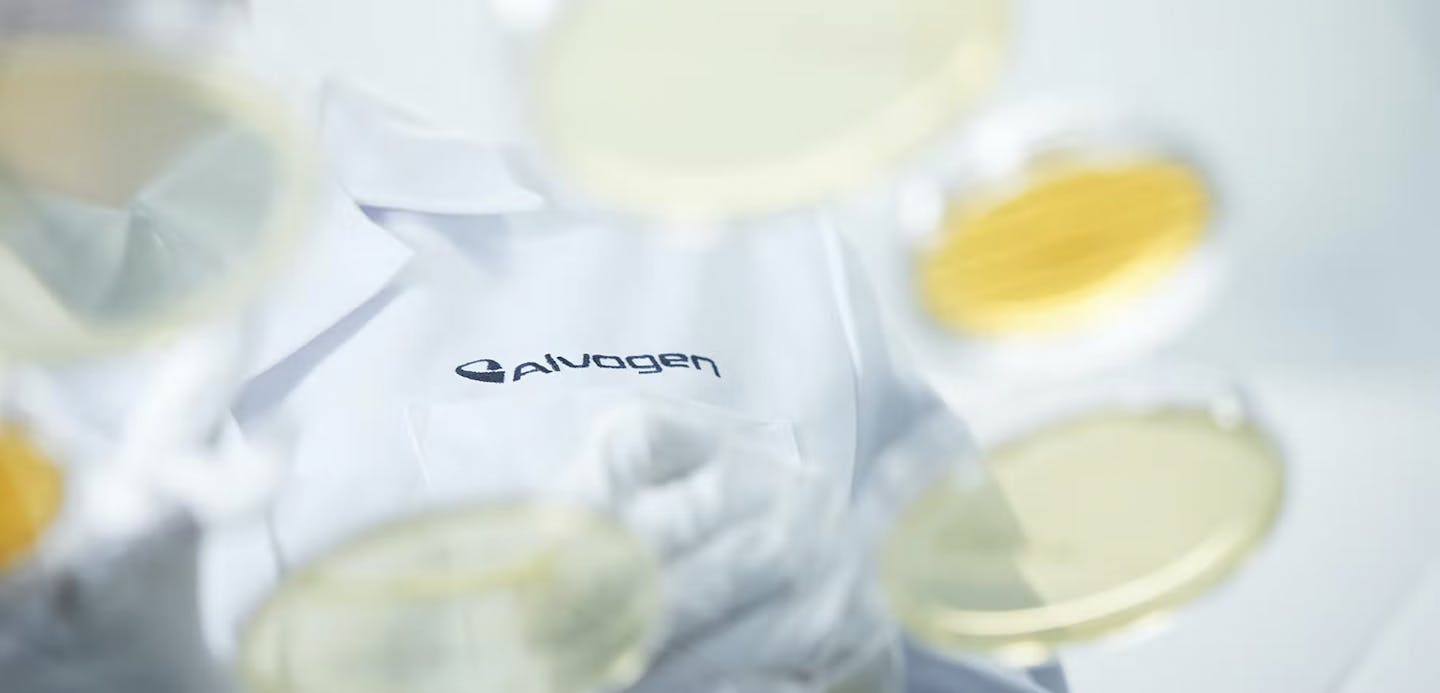
Man in Alvogen lab coat and petri dishes overlayed

Alvogen Pharma US lýkur endurfjármögnun langtímalána, lengir lánstíma og lækkar skuldsetningu
Alvogen Pharma US, Inc. (“Alvogen”) hefur lokið endurfjármögnun allra langtímalána félagsins. Nýju lánin samanstanda af 553 milljóna veðláni með gjalddaga á árinu 2028 og 116 milljóna dollara veðláni með gjalddaga á árinu 2029. Með nýju lántökunni er búið að endurfjármagna öll langtímalán félagsins, sem voru með gjalddaga síðar á þessu ári. Heildarskuldsetning lækkar um 60 milljónir dollara og jafngildir um 1,4 sinnum EBITDA framlegð síðastliðins árs.
Þá tilkynnti Alvogen einnig að lokið væri framlengingu á 240 milljóna dollara lánalínu félagsins (e. ABL revolving credit facility).
Alvogen gerir ráð fyrir því að Standard & Poors („S&P“) muni á næstu dögum gefa út nýtt lánshæfismat fyrir félagið, sem endurspegli bætta lausafjárstöðu, sterka rekstrarstöðu, lengingu lánstíma á langtímaskuldum og lækkun skuldsetningar félagsins. Þar til nýja lánshæfismatið verður gefið út, kveða reglur S&P á um að gefa þurfi út lánshæfismat til skamms tíma. Þetta skammtíma lánshæfismat endurspeglar ekki áhrif endurfjármögnunarinnar eða sterka stöðu félagsins, sem skilaði um 480 milljónum dala í framlegð á síðasta ári fyrir fjármagnsliði, skatta og afskriftir.
Lisa Graver, forstjóri Alvogen US PharmaVið erum mjög ánægð að hafa lokið þessari mikilvægu fjármögnun fyrir Alvogen, sem undirstrikar fjárhagslegan styrk félagsins, hóflega skuldsetningu til langs tíma og góða lausafjárstöðu, og viðheldur einnig nauðsynlegum sveigjanleika til að geta útfært langtímastefnu félagsins.
Fjárfestingabankarnir Goldman Sachs og Jefferies voru fjárhagslegir ráðgjafar Alvogen við viðskiptin en lögfræðistofan White & Case veitti lögfræðilega ráðgjöf.